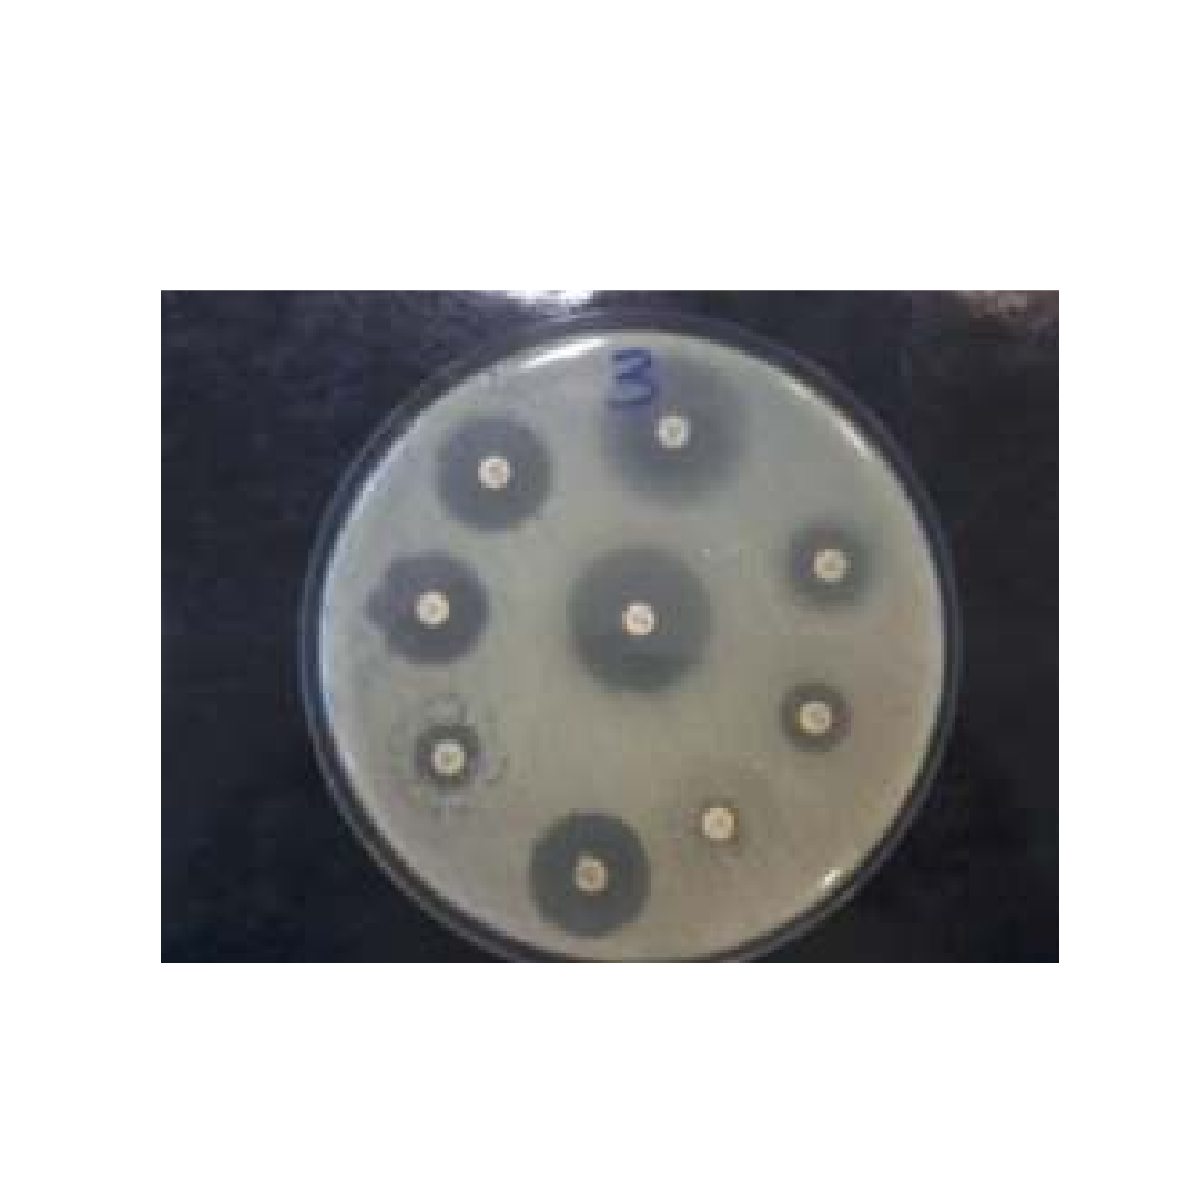
Oxoid™ Fosfomycin Antimicrobial Susceptibility Disks, 50 μg / Discos de susceptibilidad antimicrobiana a fosfomicina Oxoid™, 50 μg

Oxoid™ Fosfomycin Antimicrobial Susceptibility Disks, 50 μg / Discos de susceptibilidad antimicrobiana a fosfomicina Oxoid™, 50 μg
Determine la susceptibilidad de los microorganismos utilizando métodos AST manuales y una gama completa de discos de prueba de susceptibilidad a los antimicrobianos fáciles de usar y de alta calidad.